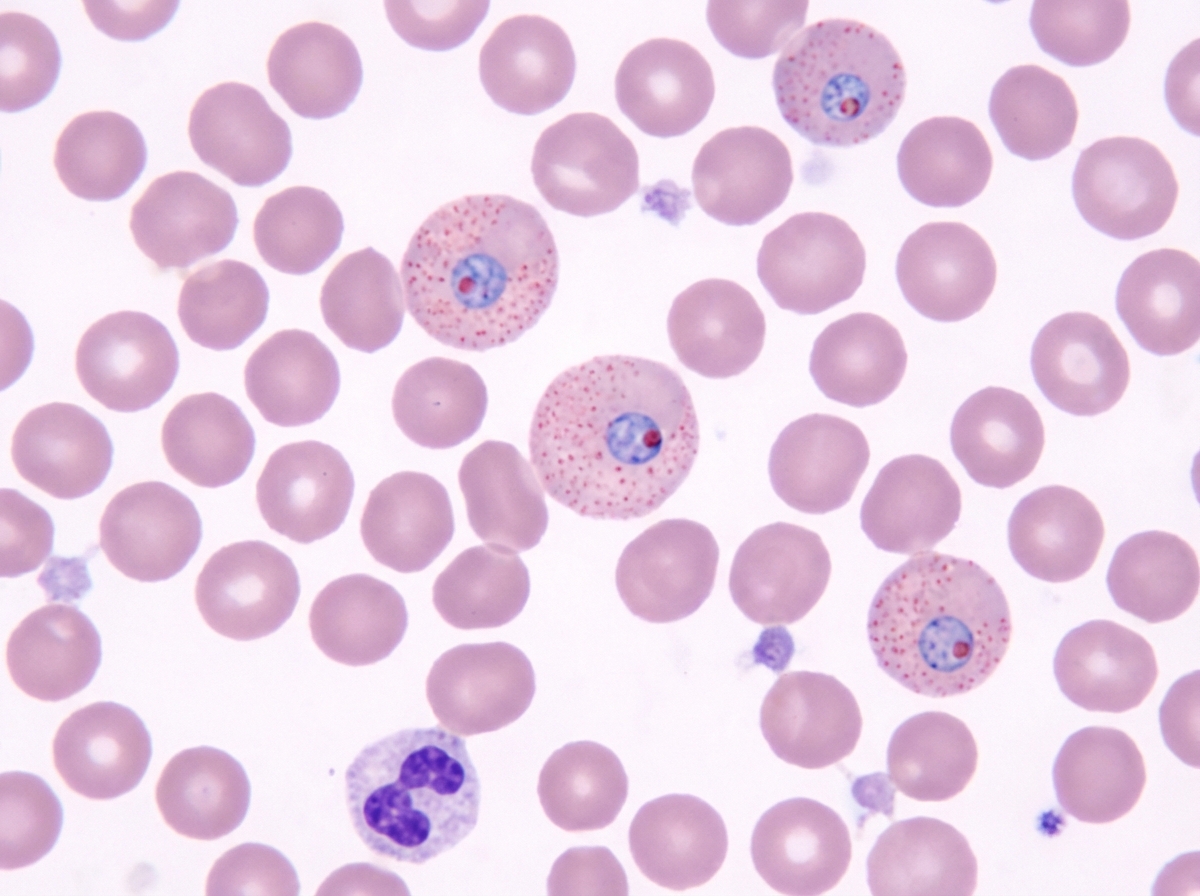
Image for question 715

What is a characteristic of anaerobic bacteria?
Mycoplasma are intrinsically resistant to which class of antibiotics?
The 23-valent pneumococcal polysaccharide vaccine (PPSV23) is recommended in all of the following conditions except:
Which of the following is the causative organism for angular conjunctivitis?
Which is the drug of choice for the following condition?
Which of the following is NOT a complication of diphtheria?
Robertson's cooked meat medium is best suited for the cultivation of which type of bacteria?
Metachromatic granules are seen in which of the following?
Which of the following statements about the Widal test in typhoid fever is true?
Which of the following describes Mycobacterium avium intracellulare?
Explanation: **Explanation:** Anaerobic bacteria are organisms that do not require oxygen for growth and, in the case of obligate anaerobes, cannot survive in its presence because they lack enzymes like **Superoxide Dismutase (SOD)** and **Catalase** to neutralize toxic oxygen free radicals. * **Option A (Fail to grow in aerobic media):** This is the defining microbiological characteristic. Anaerobes require a low oxidation-reduction potential (Eh). Exposure to atmospheric oxygen (21%) is lethal to obligate anaerobes, necessitating specialized media (e.g., Robertson’s Cooked Meat broth) and anaerobic jars/chambers for cultivation. * **Option B (Foul-smelling discharge):** Anaerobic metabolism involves the fermentation of amino acids and proteins, leading to the production of volatile short-chain fatty acids and sulfur compounds. This results in a characteristic putrid, "fecal" odor in clinical infections. * **Option C (Gas in tissue):** Many anaerobes (most notably *Clostridium perfringens*) produce gas (CO2 and H2) as a byproduct of fermentation. Clinically, this manifests as **crepitus** on palpation or gas bubbles visible on X-ray/CT scans. Since all three features are hallmark clinical and laboratory signs of anaerobic infections, **Option D** is the correct answer. **High-Yield Clinical Pearls for NEET-PG:** 1. **Polymicrobial Nature:** Most anaerobic infections (except Clostridial ones) are endogenous and polymicrobial (mixed with aerobes). 2. **Key Indicators:** Suspect anaerobes if there is infection near mucosal surfaces, abscess formation, tissue necrosis, or failure to respond to aminoglycosides (which require oxygen for uptake). 3. **Specimen Collection:** Never use a superficial swab; use needle aspiration or tissue biopsy and transport in oxygen-free containers. 4. **Common Examples:** *Bacteroides fragilis* (most common intra-abdominal), *Fusobacterium*, and *Peptostreptococcus*.
Explanation: **Explanation:** The correct answer is **Cephalosporins**. **1. Why Cephalosporins are the correct answer:** The defining characteristic of *Mycoplasma* species (including *M. pneumoniae*) is that they **lack a peptidoglycan cell wall**; they are bounded only by a triple-layered limiting membrane containing sterols. Cephalosporins, like Penicillins and other Beta-lactams, act by inhibiting cell wall synthesis (specifically the cross-linking of peptidoglycan). Since *Mycoplasma* lacks the target structure entirely, it is **intrinsically resistant** to all cell-wall-acting agents. **2. Why the other options are incorrect:** * **Aminoglycosides (A):** These inhibit the 30S ribosomal subunit. While not the first-line treatment for *Mycoplasma*, they are not intrinsically ineffective due to a lack of target. * **Macrolides (B):** These (e.g., Azithromycin, Erythromycin) inhibit the 50S ribosomal subunit. They are the **drugs of choice** for *Mycoplasma* infections. * **Tetracyclines (D):** These (e.g., Doxycycline) inhibit the 30S ribosomal subunit and are highly effective against *Mycoplasma*. **3. High-Yield Clinical Pearls for NEET-PG:** * **Smallest Free-Living Organisms:** *Mycoplasma* are the smallest organisms capable of self-replication on cell-free media. * **Culture:** They require sterols (cholesterol) for growth. On solid media (PPLO agar), they produce characteristic **"Fried Egg" colonies**. * **Gram Stain:** They do not stain on Gram stain because they lack a cell wall. * **Clinical Presentation:** *M. pneumoniae* is a leading cause of **"Walking Pneumonia"** (Atypical pneumonia) and is associated with **Cold Agglutinins** (Anti-I antibodies). * **L-forms vs. Mycoplasma:** Unlike L-forms (which are cell-wall-deficient mutants of bacteria that usually have walls), *Mycoplasma* never have the genetic capability to produce a cell wall.
Explanation: The correct answer is **C. Children less than 2 years of age**. ### **Explanation** The 23-valent pneumococcal polysaccharide vaccine (PPSV23) contains purified capsular polysaccharides. These are **T-cell independent antigens**, which require a mature splenic function and B-cell response to produce antibodies. * **The Concept:** In children under 2 years of age, the immune system is immature and cannot mount an effective response to pure polysaccharide antigens. Therefore, PPSV23 is **ineffective and contraindicated** in this age group. Instead, the **Pneumococcal Conjugate Vaccine (PCV13/15)** is used, as it is conjugated to a protein carrier, making it T-cell dependent and immunogenic in infants. ### **Analysis of Other Options** * **A. CSF Leak:** This is a high-risk condition for pneumococcal meningitis. PPSV23 is indicated (usually following a dose of PCV) to provide broad serotype coverage. * **B. Chronic Cardiac Disease:** Patients with chronic heart failure or cardiomyopathies are at increased risk for invasive pneumococcal disease (IPD) and are candidates for the vaccine. * **D. Nephrotic Syndrome:** This is an immunocompromised state characterized by the loss of antibodies and complement factors in the urine. These patients are highly susceptible to *S. pneumoniae* (the most common cause of peritonitis in nephrotic syndrome) and require vaccination. ### **NEET-PG High-Yield Pearls** * **PCV (Conjugate):** Indicated for all children <2 years (Routine immunization). It induces **mucosal immunity** (IgA) and reduces nasopharyngeal carriage (herd immunity). * **PPSV23 (Polysaccharide):** Indicated for adults >65 years and high-risk individuals >2 years (e.g., Asplenia, Sickle cell anemia, Diabetes, Chronic lung/kidney disease). * **Memory Trick:** "Polysaccharide is Poor for Puny people" (under 2 years).
Explanation: **Explanation:** **Moraxella lacunata** is the classic causative agent of **angular conjunctivitis**. This condition is characterized by chronic inflammation localized to the outer or inner angles (canthi) of the eye. The organism produces a proteolytic enzyme (protease) that macerates the epithelium of the conjunctiva and the surrounding skin, leading to the characteristic redness, excoriation, and discharge at the angles. **Analysis of Options:** * **Moraxella lacunata (Correct):** Historically known as the Morax-Axenfeld bacillus, it is a Gram-negative diplobacillus. It is uniquely associated with angular blepharoconjunctivitis. * **Moraxella catarrhalis:** Primarily a respiratory pathogen. It is a common cause of otitis media in children, acute sinusitis, and exacerbations of COPD in adults. * **Moraxella bovis:** This species is the primary cause of infectious bovine keratoconjunctivitis (pinkeye in cattle) and rarely causes disease in humans. * **Moraxella pseudogenus:** This is not a standard medically recognized species associated with human ocular pathology. **High-Yield Clinical Pearls for NEET-PG:** * **Morphology:** *Moraxella* species are Gram-negative, oxidase-positive, non-motile diplococci or diplobacilli. * **Culture:** *M. lacunata* is fastidious and grows best on **Loeffler’s serum slope**, where it produces characteristic "pitted" or "liquefied" colonies (due to proteolysis). * **Differential Diagnosis:** While *M. lacunata* is the classic cause, **Staphylococcus aureus** can also cause angular conjunctivitis. * **Treatment:** Zinc sulfate drops are traditionally used as they help neutralize the proteolytic enzymes produced by the bacteria.
Explanation: ***Chloroquine*** - **Chloroquine** is the drug of choice for **uncomplicated P. vivax malaria**, as most strains remain sensitive to this agent. - It effectively treats the **blood stage** of the parasite and is well-tolerated with fewer side effects compared to other antimalarials. *Quinine* - **Quinine** is reserved for **severe malaria** or **chloroquine-resistant P. falciparum**, not for uncomplicated P. vivax. - It has significant **side effects** including cinchonism (tinnitus, headache, nausea) and requires careful monitoring. *Clindamycin* - **Clindamycin** is primarily used for **babesiosis** or as **combination therapy** with quinine for severe malaria. - It is not a first-line treatment for **P. vivax malaria** and lacks the specific efficacy of chloroquine for this species. *Dapsone* - **Dapsone** is the drug of choice for **leprosy** (Hansen's disease) caused by Mycobacterium leprae. - It has no role in **malaria treatment** and belongs to a different class of antimicrobial agents (sulfones).
Explanation: The pathogenesis of **Diphtheria** is primarily mediated by the **Diphtheria toxin**, an exotoxin produced by *Corynebacterium diphtheriae*. This toxin inhibits protein synthesis by inactivating Elongation Factor-2 (EF-2) via ADP-ribosylation. While the infection starts locally (pseudomembrane), the toxin spreads hematogenously, targeting specific tissues with high receptor density. **Explanation of the Correct Answer:** * **D. Hepatic failure:** This is the correct answer because the Diphtheria toxin specifically targets the **heart** and the **nervous system**. It does not typically cause significant parenchymal damage to the liver or lead to hepatic failure. **Explanation of Incorrect Options:** * **A. Myocarditis:** This is the most serious complication, usually occurring in the 2nd week. It can lead to heart failure and arrhythmias (ST-T wave changes are common). * **B. Ocular muscle palsy:** Neurological complications (post-diphtheritic paralysis) occur later. **Palatal palsy** is the most common, but **ciliary muscle paralysis** (leading to loss of accommodation) and extraocular muscle palsies are well-documented. * **C. Cerebellar ataxia:** While less common than peripheral neuropathy, toxin-mediated damage can involve various parts of the nervous system, including rare presentations of ataxia or polyneuritis mimicking Guillain-Barré syndrome. **High-Yield Clinical Pearls for NEET-PG:** * **Schick Test:** Used to demonstrate immunity/susceptibility to diphtheria. * **Culture Media:** Löffler's serum slope (rapid growth) and Potassium Tellurite agar (black colonies). * **Staining:** Albert’s stain shows metachromatic granules (Volutin/Babes-Ernst granules). * **Treatment Priority:** Anti-Diphtheritic Serum (ADS) must be given immediately to neutralize unbound toxin; antibiotics (Penicillin/Erythromycin) only stop further toxin production.
Explanation: **Explanation:** **Robertson’s Cooked Meat (RCM) medium** is the classic enrichment and storage medium used for the cultivation of **obligate anaerobes**, specifically the genus **Clostridia**. **Why Clostridia is correct:** The medium contains sterilized minced beef heart muscle, which provides unsaturated fatty acids and glutathione. These act as **reducing agents**, effectively removing dissolved oxygen from the medium. This creates a low redox potential environment necessary for the growth of anaerobes like *Clostridium tetani* and *Clostridium perfringens*. Additionally, RCM allows for the differentiation of Clostridia based on their metabolic activity: * **Proteolytic species** (e.g., *C. tetani*): Turn the meat black and produce a foul smell. * **Saccharolytic species** (e.g., *C. perfringens*): Turn the meat pink/red. **Why other options are incorrect:** * **Staphylococcus epidermidis:** A facultative anaerobe that grows easily on routine media like Blood Agar or Nutrient Agar; it does not require specialized anaerobic media. * **Vibrio cholerae:** An aerobic/facultative anaerobic bacterium that requires alkaline conditions. The gold standard medium is **TCBS** (Thiosulfate-Citrate-Bile Salts-Sucrose) agar. * **Mycobacterium:** These are obligate aerobes and require lipid-rich media like **Lowenstein-Jensen (LJ)** medium for growth. **High-Yield NEET-PG Pearls:** * **Indicator:** If an indicator is used in anaerobic jars, **Methylene Blue** is common (remains colorless in anaerobic conditions). * **Storage:** RCM is excellent for the long-term preservation of stock cultures. * **Pink Meat:** Think *C. perfringens* (Saccharolytic). * **Black Meat:** Think *C. tetani* or *C. botulinum* (Proteolytic).
Explanation: **Explanation:** Metachromatic granules (also known as **Volutin or Babes-Ernst granules**) are intracellular storage polymers of inorganic polyphosphates. They appear as distinct reddish-purple granules when stained with blue dyes (like Methylene blue or Albert’s stain) due to the phenomenon of **metachromasia**, where the dye changes color upon binding to the highly concentrated phosphate chains. **Analysis of Options:** * **Corynebacterium diphtheriae:** This is the classic example. These granules are a hallmark feature used for presumptive diagnosis, typically arranged in a "cuneiform" or Chinese-letter pattern. * **Gardnerella vaginalis:** This pleomorphic gram-variable rod, associated with bacterial vaginosis, also demonstrates metachromatic granules, a fact often tested in higher-difficulty NEET-PG questions. * **Arsenophonus:** This is a genus of Gram-negative bacteria (endosymbionts of insects) that also exhibits these storage granules. While *Corynebacterium* is the most famous example, several other organisms like *Mycobacterium*, *Spirillum volutans*, and certain fungi also possess them. Therefore, **"All of the above"** is the correct choice. **High-Yield Clinical Pearls for NEET-PG:** * **Special Stains:** Albert’s, Neisser’s, and Ponder’s stains are used specifically to demonstrate these granules. * **Composition:** They are composed of **polymetaphosphate**. * **Function:** They serve as a reserve source of energy and phosphate. * **Differential Diagnosis:** Do not confuse metachromatic granules with Bipolar staining (seen in *Yersinia pestis* - "Safety pin appearance").
Explanation: ### Explanation **Correct Answer: C. Previous infection alters Widal test results.** The Widal test is a serological test that detects antibodies (agglutinins) against the H (flagellar) and O (somatic) antigens of *Salmonella typhi* and *S. paratyphi*. The correct answer is **C** because the Widal test measures the presence of antibodies, not the pathogen itself. Individuals who have had a previous infection may carry residual antibodies (anamnestic response), leading to a baseline titer that can cause a false-positive result during a current, unrelated febrile illness. #### Analysis of Incorrect Options: * **A. The Widal test is considered confirmative:** In endemic areas like India, the Widal test is only **presumptive**. The gold standard for confirmation is **blood culture** (during the 1st week) or bone marrow culture. * **B. Antibiotic treatment does not alter results:** Early administration of antibiotics can suppress the antibody response, leading to a **false-negative** Widal result. * **D. Not affected by prior vaccination:** Immunization with the TAB vaccine or live oral typhoid vaccines induces antibody production, which can lead to high titers in the Widal test, complicating the diagnosis. #### High-Yield Clinical Pearls for NEET-PG: * **Timing:** The Widal test usually becomes positive after the **1st week** of fever (maximal in the 3rd week). * **Diagnostic Titer:** A **four-fold rise** in paired sera (taken 7–10 days apart) is more significant than a single high titer. * **Antigens:** 'O' agglutinins appear early and disappear early (indicates recent infection); 'H' agglutinins appear late and persist longer. * **False Positives:** Can occur in cases of malaria, typhus, and chronic liver disease.
Explanation: **Explanation:** *Mycobacterium avium-intracellulare* complex (MAC) is classified under the **Runyon Classification** of Non-Tuberculous Mycobacteria (NTM). The Runyon classification categorizes NTM based on their rate of growth and their ability to produce pigment in the presence or absence of light. 1. **Why Option A is Correct:** MAC belongs to **Runyon Group III (Non-photochromogens)**. These organisms produce little to no pigment, and their coloration does not change regardless of whether they are grown in the light or the dark. They typically appear as buff-colored or off-white colonies on Lowenstein-Jensen (LJ) medium. 2. **Why Other Options are Incorrect:** * **Photochromogens (Group I):** Produce pigment only when exposed to light (e.g., *M. kansasii*, *M. marinum*). * **Scotochromogens (Group II):** Produce pigment in both light and dark conditions (e.g., *M. scrofulaceum*, *M. szulgai*). * **Rapid Growers (Group IV):** Form visible colonies within 7 days (e.g., *M. fortuitum*, *M. chelonae*, *M. abscessus*). MAC is a slow grower, taking 2–4 weeks to culture. **Clinical Pearls for NEET-PG:** * **MAC and HIV:** It is the most common opportunistic bacterial infection in AIDS patients, typically occurring when the **CD4 count falls below 50 cells/mm³**. * **Prophylaxis:** Azithromycin or Clarithromycin is used for primary prophylaxis in severely immunocompromised patients. * **Clinical Presentation:** In immunocompetent hosts, it can cause "Lady Windermere syndrome" (right middle lobe bronchiectasis) or "Hot tub lung" (hypersensitivity pneumonitis). * **Diagnosis:** MAC is often resistant to standard anti-tubercular drugs (RIPE); treatment usually involves a macrolide combined with ethambutol and a rifamycin.
Staphylococci
Practice Questions
Streptococci and Enterococci
Practice Questions
Neisseria and Moraxella
Practice Questions
Corynebacterium and Listeria
Practice Questions
Bacillus and Clostridium
Practice Questions
Enterobacteriaceae
Practice Questions
Vibrio, Aeromonas, and Plesiomonas
Practice Questions
Pseudomonas and Related Bacteria
Practice Questions
Haemophilus and HACEK Group
Practice Questions
Bordetella and Brucella
Practice Questions
Mycobacteria
Practice Questions
Spirochetes
Practice Questions
Get full access to all questions, explanations, and performance tracking.
Start For Free